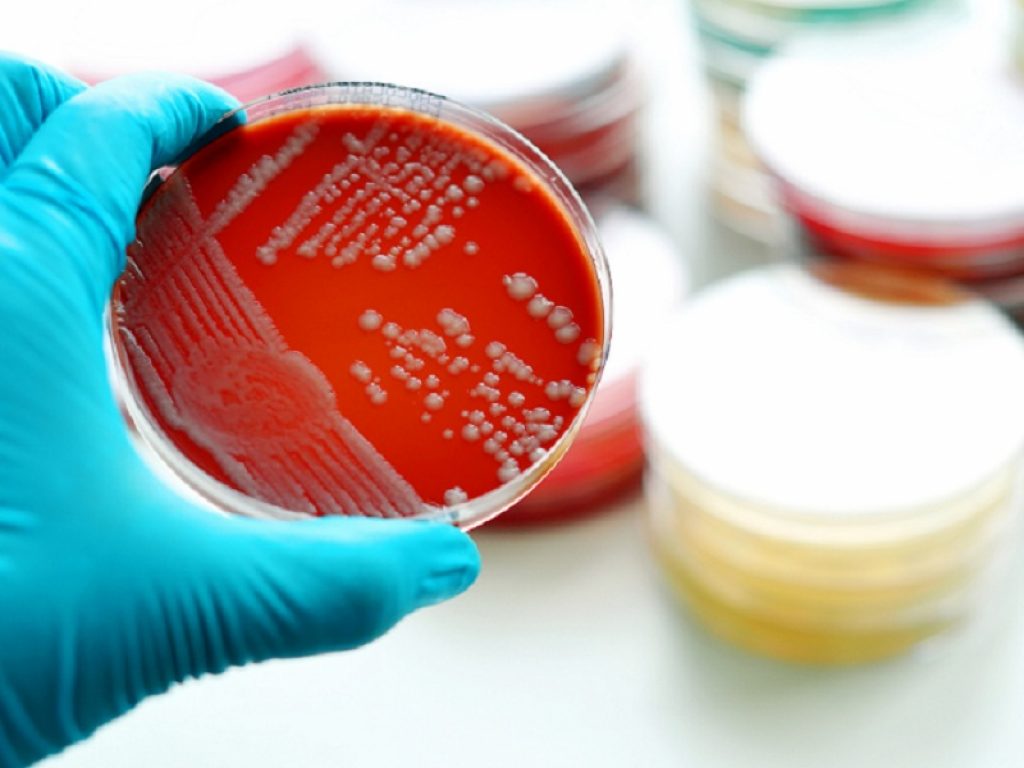

Antibiotico-resistenza e ruolo del farmacista ospedaliero: SITA, Bocconi e Shionogi danno il via al progetto STAR
Definire un’appropriata gestione delle infezioni antimicrobiche correlate all’assistenza, supportare un’azione tempestiva e l’appropriatezza terapeutica verso i pazienti critici con limitate opzioni di trattamento e assicurare un allineamento tra i professionisti sanitari coinvolti in tutto il processo di cura, puntando sul ruolo chiave del farmacista ospedaliero. Sono questi gli obiettivi della prima edizione del Programma di STewardship e Antibiotico-Resistenza (STAR), un programma di formazione manageriale che mira a rafforzare le competenze richieste a questo ruolo per fornire un contributo sempre più attivo nei team di stewardship ospedalieri e che nasce dalla collaborazione tra la Società Italiana di Terapia Antinfettiva (SITA), SDA Bocconi ed è interamente finanziato con il contributo non condizionante di Shionogi Italia.
Per le sue competenze professionali, il farmacista ospedaliero è tra gli operatori sanitari che rivestono un ruolo cruciale nelle decisioni di cura e nell’assistenza dei pazienti e che deve intervenire attivamente nella stewardship antimicrobica, contribuendo a migliorare la rete di monitoraggio continuo e interconnesso con gli attuali sistemi di sorveglianza microbiologica.
La necessità di rafforzare tutto il sistema di gestione, controllo e monitoraggio all’interno delle strutture ospedaliere diventa ogni giorno più urgente poiché la resistenza agli antibiotici (AMR) è un problema in continua crescita a livello globale, ma con un impatto significativo soprattutto nel nostro Paese: in Italia, infatti, le infezioni causate da batteri antibiotico-resistenti costano la vita a oltre 10mila persone ogni anno e ci posizionano ai primi posti in Europa per numero di decessi, dove contribuiamo per oltre un terzo sia alla mortalità causata da AMR sia ai casi di infezioni nosocomiali dell’intera UE.
“L’antibiotico-resistenza rappresenta una delle minacce più gravi alla salute mondiale, e senza misure di contrasto adeguate si stima provocherà circa 10 milioni di morti entro il 2050. Le infezioni causate da patogeni multi-resistenti costituiscono una forte criticità per i pazienti già vulnerabili a causa di altre patologie e un gravoso peso per il nostro Sistema Sanitario” – commenta Matteo Bassetti, Professore Ordinario di Malattie Infettive dell’Università di Genova e Presidente SITA.
“Negli ospedali la possibilità di trasmissione dell’AMR viene amplificata. Qui le infezioni correlate all’assistenza sono causate dai cosiddetti ‘super batteri’, patogeni Gram-negativi multi-resistenti e resistenti ai carbapenemi – come Acinetobacter baumannii, Klebsiella pneumoniae, Pseudomonas aeruginosa e Enterobacterales – considerati di priorità critica dall’Organizzazione Mondiale della Sanità. Questi batteri sono il principale fattore di fallimento del trattamento delle infezioni, e causano un aumento della morbilità, il prolungamento delle degenze ospedaliere e l’incremento della mortalità”.
Le infezioni causate da patogeni multi-resistenti arrecano quindi il burden sanitario ed economico maggiore. In questo contesto così critico, da un lato, la disponibilità di antibiotici innovativi è fondamentale per contrastare in maniera efficace il fenomeno dell’AMR; dall’altro, è altrettanto cruciale adottare una gestione appropriata e mirata della terapia antibiotica al fine di evitare lo sviluppo di ulteriori resistenze anche rispetto ai nuovi farmaci antibiotici.
“Il programma che abbiamo messo a punto si pone l’obiettivo di accrescere le competenze dei farmacisti ospedalieri nell’ambito dell’infettivologia e dell’HTA applicata all’antibiotico-terapia, affinché questi professionisti acquisiscano nuovi strumenti e competenze utili alla corretta valutazione e gestione dei nuovi antibiotici all’interno della loro pratica clinica quotidiana” – spiega Claudio Jommi, Professor of Practice di Government, Health e Not for Profit presso SDA Bocconi School of Management.
“I temi che saranno affrontati mirano a focalizzare l’attenzione del farmacista ospedaliero su aspetti pratici e concreti che impattano il paziente, come gli unmet need e i benefici attesi nella sua prospettiva, e il sistema sanitario. Le decisioni sulla scelta degli antibiotici si baseranno quindi su valutazioni e analisi oggettive che riguardano la stima dei costi emergenti e cessanti delle terapie antibiotiche, i costi delle cure e il rapporto di costo-efficacia”.
Il programma STAR, che vede la partecipazione di circa 25 farmacisti ospedalieri provenienti dalle diverse Regioni, avrà una durata di sei mesi e si apre con una sessione di formazione frontale dal 30 Novembre al 2 Dicembre, erogata interamente a distanza nel rispetto delle vigenti disposizioni anti-COVID. Successivamente i partecipanti, suddivisi in quattro gruppi, lavoreranno nello sviluppo di altrettanti progetti di campo (Field Research Project), assegnati dalla Segreteria Scientifica del Programma STAR e con la mentorship di alcune delle Faculties del Programma stesso, che verranno infine presentati nel Workshop che concluderà questa prima edizione del programma prevista a Milano per il prossimo Maggio 2021.
Il farmacista ospedaliero è la figura che vive in prima persona la sfida che il Servizio sanitario nazionale sta affrontando rispetto all’AMR e che ha un punto di vista ampio sull’intero processo di cura: è determinante nella definizione delle linee terapeutiche, nella gestione della terapia antibiotica e nel monitoraggio dei nuovi farmaci che, come nel caso degli antibiotici di nuova generazione, possono contribuire anche alla sostenibilità del SSN.
Insieme all’infettivologo e al microbiologo ospedaliero, il farmacista può dare una linea di indirizzo e guidare i programmi di amministrazione antibiotica prevedendo l’attuazione di misure congiunte ai vari livelli, promuovendo l’educazione a un uso appropriato degli antibiotici e azioni di prevenzione delle infezioni e di controllo in ambito ospedaliero.
“Il corso mette a fuoco criticità e nuove opportunità per fronteggiare un fenomeno che sta mettendo in seria difficoltà il sistema sanitario-assistenziale e la sua capacità offrire cure adeguate, efficaci e tempestive a pazienti già critici e che a causa delle resistenze possono giungere a esiti fatali” – interviene Francesco Cattel, Direttore della S.C. Farmacia Ospedaliera Città della Salute e della Scienza di Torino e membro SITA.
“Oltre a nuovi antibiotici in grado di agire su ceppi resistenti, fondamentali per offrire una nuova prospettiva di cura a questi pazienti, vi è anche la necessità di accrescere la positiva interazione tra farmacisti ospedalieri, infettivologi e microbiologi. Solo attraverso un approccio integrato di competenze trasversali sarà possibile mettere in atto misure congiunte e strategie di azioni con un indirizzo univoco e tempestivo, ispirate all’appropriatezza dell’uso di antibiotici e alla volontà di limitare il possibile sviluppo di ulteriori resistenze”.